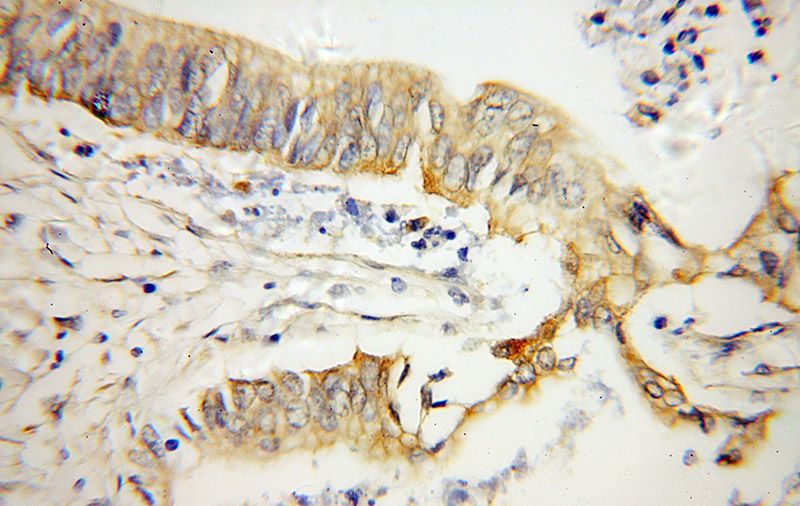
Immunohistochemical of paraffin-embedded human pancreas cancer using Catalog No:113415(OPTN antibody) at dilution of 1:50 (under 40x lens)

-
Product Name
OPTN antibody
- Documents
-
Description
OPTN Rabbit Polyclonal antibody. Positive IHC detected in human pancreas cancer tissue, human brain tissue. Positive IF detected in MCF-7 cells. Positive FC detected in MCF-7 cells. Positive IP detected in mouse brain tissue. Positive WB detected in HeLa cells, mouse brain tissue, mouse testis tissue. Observed molecular weight by Western-blot: 66 kDa
-
Tested applications
ELISA, WB, IHC, IF, IP, FC
-
Species reactivity
Human,Mouse,Rat; other species not tested.
-
Alternative names
E3 14.7K interacting protein antibody; FIP 2 antibody; FIP2 antibody; GLC1E antibody; HIP 7 antibody; HIP7 antibody; Huntingtin yeast partner L antibody; HYPL antibody; NEMO related protein antibody; NRP antibody; optineurin antibody; OPTN antibody; TFIIIA INTP antibody
-
Isotype
Rabbit IgG
-
Preparation
This antibody was obtained by immunization of OPTN recombinant protein (Accession Number: NM_001008212). Purification method: Antigen affinity purified.
-
Clonality
Polyclonal
-
Formulation
PBS with 0.1% sodium azide and 50% glycerol pH 7.3.
-
Storage instructions
Store at -20℃. DO NOT ALIQUOT
-
Applications
Recommended Dilution:
WB: 1:500-1:5000
IP: 1:200-1:2000
IHC: 1:20-1:200
IF: 1:10-1:100
-
Validations

HeLa cells were subjected to SDS PAGE followed by western blot with Catalog No:113415(OPTN antibody) at dilution of 1:800

IP Result of anti-OPTN (IP:Catalog No:113415, 3ug; Detection:Catalog No:113415 1:800) with mouse brain tissue lysate 8000ug.

Immunohistochemical of paraffin-embedded human pancreas cancer using Catalog No:113415(OPTN antibody) at dilution of 1:50 (under 10x lens)
Immunohistochemical of paraffin-embedded human pancreas cancer using Catalog No:113415(OPTN antibody) at dilution of 1:50 (under 40x lens)

Immunofluorescent analysis of MCF-7 cells, using OPTN antibody Catalog No:113415 at 1:25 dilution and Rhodamine-labeled goat anti-rabbit IgG (red).

1X10^6 MCF-7 cells were stained with 0.2ug OPTN antibody (Catalog No:113415, red) and control antibody (blue). Fixed with 4% PFA blocked with 3% BSA (30 min). Alexa Fluor 488-congugated AffiniPure Goat Anti-Rabbit IgG(H+L) with dilution 1:1500.
-
Background
OPTN, also named as FIP2, GLC1E, HIP7, HYPL and NRP, plays a neuroprotective role in the eye and optic nerve. It is probably part of the TNF-alpha signaling pathway that can shift the equilibrium toward induction of cell death. OPTN may act by regulating membrane trafficking and cellular morphogenesis via a complex that contains Rab8 and hungtingtin (HD). OPTN may constitute a cellular target for adenovirus E3 14.7, an inhibitor of TNF-alpha functions, thereby affecting cell death. Defects in OPTN are the cause of primary open angle glaucoma type 1E (GLC1E). Defects in OPTN are a cause of susceptibility to normal pressure glaucoma (NPG). OPTN mutated in adult-onset primary open angle glaucoma. It supports the protective role of OPTN in the trabecular meshwork.
-
References
- Slowicka K, Vereecke L, McGuire C. Optineurin deficiency in mice is associated with increased sensitivity to Salmonella but does not affect proinflammatory NF-κB signaling. European journal of immunology. 2015.
- Osawa T, Mizuno Y, Fujita Y, Takatama M, Nakazato Y, Okamoto K. Optineurin in neurodegenerative diseases. Neuropathology : official journal of the Japanese Society of Neuropathology. 31(6):569-74. 2011.
- Meng Q, Xiao Z, Yuan H. Transgenic mice with overexpression of mutated human optineurin(E50K) in the retina. Molecular biology reports. 39(2):1119-24. 2012.
- Wang C, Hosono K, Ohtsubo M. Interaction between optineurin and the bZIP transcription factor NRL. Cell biology international. 38(1):16-25. 2014.
- Gao J, Ohtsubo M, Hotta Y, Minoshima S. Oligomerization of optineurin and its oxidative stress- or E50K mutation-driven covalent cross-linking: possible relationship with glaucoma pathology. PloS one. 9(7):e101206. 2014.
- Tao Z, Wang H, Xia Q. Nucleolar stress and impaired stress granule formation contribute to C9orf72 RAN translation-induced cytotoxicity. Human molecular genetics. 24(9):2426-41. 2015.
- Lazarou M, Sliter DA, Kane LA. The ubiquitin kinase PINK1 recruits autophagy receptors to induce mitophagy. Nature. 524(7565):309-14. 2015.
Related Products / Services
Please note: All products are "FOR RESEARCH USE ONLY AND ARE NOT INTENDED FOR DIAGNOSTIC OR THERAPEUTIC USE"
